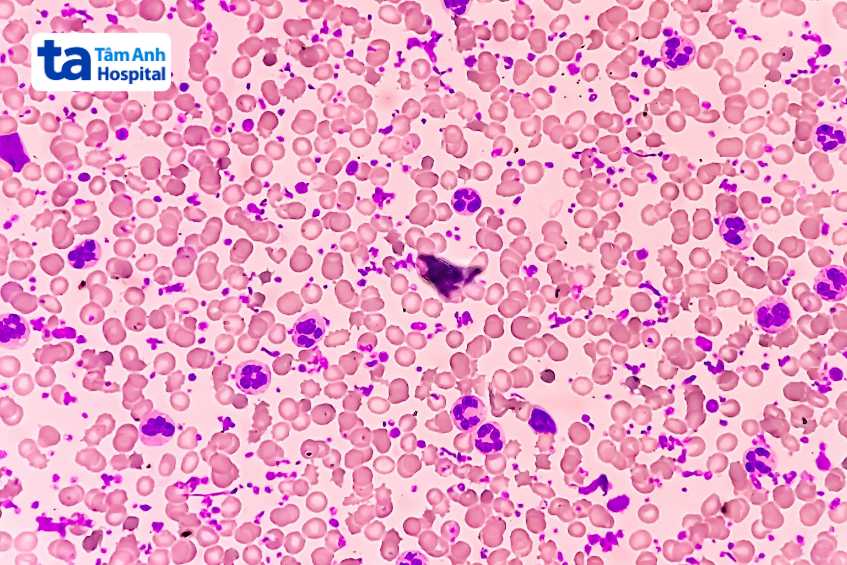
tăng tiểu cầu tiên phát trong máu

Tăng tiểu cầu tiên phát là bệnh về máu ác tính, gây ảnh hưởng đến sức khỏe và tiềm tàng nhiều rủi ro nếu không được chẩn đoán và điều trị kịp thời. Vậy, tăng tiểu cầu tiên phát là gì? Điều trị bệnh bằng cách nào?

Tăng tiểu cầu tiên phát (essential thrombocythemia) là bệnh thuộc nhóm tăng sinh ác tính, được xem như một dạng tiền ung thư máu, tiềm ẩn nhiều rủi ro sức khỏe nếu không được chữa trị kịp thời. Bệnh lý này ít phổ biến, là một rối loạn mãn tính thuộc nhóm bệnh lý tăng sinh tủy, được đặc trưng bởi tình trạng tăng sinh tiểu cầu ở máu ngoại vi và mẫu tiểu cầu trong tủy xương.
Trong máu chứa 3 loại tế bào chính đảm nhiệm vai trò khác nhau, bao gồm tiểu cầu, bạch cầu và hồng cầu. Trong đó, tiểu cầu là tế bào tham gia trực tiếp vào quá trình đông máu của cơ thể, giúp cầm máu giúp hạn chế nguy cơ bị xuất huyết quá mức.
Ở trạng thái khỏe mạnh, mỗi microlit máu (mcL) của cơ thể chứa khoảng 150,000 – 450,000 tế bào tiểu cầu, nếu vượt ngưỡng 450,000 tế bào / mcL thì được chẩn đoán là tình trạng tăng tiểu cầu [1].
>> Tham khảo thêm: Bệnh tăng tiểu cầu có nguy hiểm không?
Tăng tiểu cầu tiên phát (tăng tiểu cầu nguyên phát) bắt nguồn từ tình trạng tăng sinh mất kiểm soát các megakaryocyte – tế bào “mẹ” tạo nên tiểu cầu trong tủy xương. Điều này khiến cho dòng tiểu cầu tăng cao ngoài tầm kiểm soát của cơ thể. Trường hợp tăng tiểu cầu không rõ nguyên nhân thường chiếm đa số.
Ngoài ra, một số trường hợp nguyên nhân gây tăng tiểu cầu tiên phát có thể liên quan đến gen JAK2, CALR và MPL [2], cụ thể:
Khi xảy ra đột biến, các gen này sẽ tạo ra phản ứng dây chuyền khiến tủy xương sản xuất tế bào quá mức, dẫn đến tăng tiểu cầu mất kiểm soát.
>> Tìm hiểu: Tăng tiểu cầu có phải là ung thư máu?
Tùy thuộc vào mức độ tăng tiểu cầu, triệu chứng tăng tiểu cầu tiên phát có thể khác nhau ở từng trường hợp. Bệnh lý này cũng có thể không gây ra bất kỳ triệu chứng nào cho đến khi các cục máu đông được hình thành tại các cơ quan trong cơ thể, đó có thể là não bộ, tay, chân… Khi đó, người bệnh tăng tiểu cầu nguyên phát có thể gặp phải các triệu chứng như:

Để chẩn đoán chính xác tình trạng tăng tiểu cầu tiên phát, người bệnh cần trải qua quá trình thăm khám lâm sàng và thực hiện một số xét nghiệm dưới chỉ định của bác sĩ. Thông qua quá trình thăm khám lâm sàng, bác sĩ sẽ ghi nhận bệnh sử, triệu chứng của bệnh (nếu có). Sau đó, để có đủ cơ sở đưa ra chẩn đoán bệnh tăng tiểu cầu nguyên phát, bác sĩ sẽ chỉ định một số xét nghiệm bao gồm:
Tùy thuộc vào mức độ tăng tiểu cầu, bác sĩ sẽ đưa ra phác đồ điều trị tăng tiểu cầu nguyên phát phù hợp. Phác đồ điều trị bệnh lý này bao gồm các loại thuốc với tác dụng ngăn ngừa hình thành huyết khối và làm giảm lượng tiểu cầu trong máu, cụ thể gồm:
Ngoài ra, để kịp thời làm giảm lượng tiểu cầu tăng quá mức trong máu, bác sĩ có thể chỉ định người bệnh thực hiện thủ thuật lọc tiểu cầu hay còn gọi là gạn tách tiểu cầu.
Nếu không được điều trị kịp thời, bệnh tăng tiểu cầu nguyên phát có thể dẫn đến hình thành cục máu đông, xuất huyết nghiêm trọng, tiềm ẩn nhiều rủi ro về sức khỏe, thậm chí đe dọa tính mạng của người bệnh. Ngoài ra, bệnh lý này có thể diễn biến âm thầm, không gây ra bất kỳ triệu chứng nào, khiến cho quá trình chẩn đoán và điều trị bệnh bị chậm trễ, ảnh hưởng nghiêm trọng đến sức khỏe của người bệnh.
Tăng tiểu cầu tiên phát nếu không được điều trị kịp thời và đúng cách có thể dẫn đến nhiều biến chứng nguy hiểm như:
Hút thuốc gây ảnh hưởng tiêu cực đến sức khỏe, đặc biệt là người mắc bệnh tăng tiểu cầu. Thuốc lá là tác nhân làm giảm lưu lượng máu cung cấp oxy trong hệ tuần hoàn, làm tăng phản ứng mạch máu, ảnh hưởng nghiêm trọng đến hoạt động của hệ tim mạch. Hút thuốc lá còn gây tăng fibrinogen, tăng kết dính tiểu cầu, dẫn đến hình thành cục máu đông, tiềm ẩn nhiều biến chứng nguy hiểm như đột quỵ não, nhồi máu cơ tim…

Người bệnh tăng tiểu cầu nên duy trì tập luyện bằng các môn thể thao phù hợp như bơi lội, đạp xe, chạy bộ, tập gym… từ 30 phút mỗi ngày với tần suất ít nhất 3 lần mỗi tuần. Hoạt động thể chất sẽ góp phần nâng cao sức khỏe tổng thể, hạn chế nguy cơ hình thành cục máu đông, giúp nâng cao hiệu quả chữa trị bệnh tăng tiểu cầu.
Người bệnh tăng tiểu cầu cần định kỳ kiểm tra, khám sức khỏe tổng quát và tái khám theo chỉ định của bác sĩ. Từ đó, bác sĩ có thể đánh giá hiệu quả phác đồ điều trị và dự phòng được nguy cơ khởi phát biến chứng, đưa ra hướng điều trị phù hợp, hiệu quả.
Tăng tiểu cầu nguyên phát là bệnh lý về máu ác tính, được xem như một dạng tiền ung thư máu. Tuy nhiên, khi so với các loại ung thư máu khác, tiên lượng của bệnh lý này tương đối khả quan nếu được chữa trị kịp thời và đúng cách.
Nếu được chẩn đoán sớm và điều trị kịp thời, người bị tăng tiểu cầu tiên phát vẫn có thể sống khỏe mạnh. Mặt khác, chậm trễ trong điều trị tăng tiểu cầu tiên phát có thể ảnh hưởng nghiêm trọng đến sức khỏe, dẫn đến nhiều biến chứng nguy hiểm đe dọa tính mạng của người bệnh.

Tăng tiểu cầu tiên phát và tăng tiểu cầu thứ phát khác nhau về các yếu tố, gồm:
Ngoài đột biến gen, các nguyên nhân khác gây bệnh tăng tiểu cầu nguyên phát vẫn chưa được xác định cụ thể. Vì vậy, các biện pháp phòng ngừa được áp dụng với mục đích giúp người bệnh tăng tiểu cầu tiên pháp kiểm soát yếu tố gây hình thành huyết khối như tăng cholesterol máu, tăng huyết áp, bệnh đái tháo đường…, ngăn chặn nguy cơ biến chứng nguy hiểm.
Đặt lịch thăm khám và điều trị bệnh tiểu cầu tại khoa Nội Tổng hợp, BVĐK Tâm Anh vui lòng liên hệ:
HỆ THỐNG BỆNH VIỆN ĐA KHOA TÂM ANH
Như vậy, bài viết đã cung cấp những thông tin góp phần làm rõ các vấn đề xoay quanh bệnh lý tăng tiểu cầu tiên phát. Bệnh lý này có thể không có biểu hiện cụ thể, vì vậy mỗi người nên duy trì thăm khám sức khỏe định kỳ 2 lần / năm, khám sức khỏe về máu (huyết học) để sớm phát hiện và điều trị bệnh kịp thời.